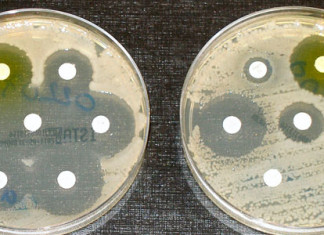
Nueva diana en la lucha contra la ‘superbacteria’

Cirugía mejora el trastorno por la compresión del nervio
Dos nuevos estudios de la Universidad de Washington sugiere formas de mejorar el tratamiento quirúrgico de los problemas causados por los nervios comprimidos en...
Granjero chino mantiene su hijo vivo con un ventilador casero de...
Una familia de pobres campesinos chinos han sido inundada con donaciones cuando se supo que había mantenido con vida a su hijo paralizado durante...
Los gérmenes se propagan rápidamente en el trabajo
Cuando alguien va a trabajar enfermo, casi el 50% de todas las superficies que se toca en la oficina se infecta con el virus...
Beber en exceso aumenta el riesgo de diabetes tipo 2 al...
Consumo excesivo de alcohol causa resistencia a la insulina, lo que aumenta el riesgo de diabetes tipo 2, según los resultados de un estudio...
El yoga ayuda al trastorno del ritmo cardíaco
Las personas con un problema de ritmo cardíaco común pueden ser capazes de disminuir sus síntomas mediante la adición de yoga a su régimen...
Nueva diana en la esclerosis múltiple y la enfermedad de Alzheimer
Investigadores de la Boston University School of Medicine (BUSM), dirigidos por Carmela Abraham, PhD, profesora de bioquímica, junto con Cidi Chen, PhD, y otros...
Mujer argentina da a luz después de trasplante de corazón
Una argentina con un corazón trasplantado dio a luz a una niña después de un tratamiento de fertilización in vitro.
El embarazo después de un...
Nueva diana en la lucha contra la ‘superbacteria’
Investigadores de University of Cambridge han descubierto cómo una superbacteria resistente a los antibióticos explota oxígeno en limitadas condiciones de los pulmones de pacientes...
Exsmokers, «Los ex fumadores no abandonan»
Desde el 1 de diciembre los fumadores de Europa que se lo han propuesto pueden dejar de fumar gracias a la iniciativa conjunta de...
Páncreas artificial, un paso más para pacientes con diabetes tipo 1
Para los pacientes con diabetes de tipo 1, un sistema de doble hormona pancreática artificial (también conocido como un sistema de suministro de circuito...
Las células gliales asisten en la reparación de los nervios lesionados
Cuando un nervio está dañado, las células gliales producen la proteína neuregulin1 y de ese modo ayudan a promover la regeneración del tejido nervioso.
A...
Estudio demuestra beneficios de salud en «salir del armario»
Lesbianas, gays y bisexuales (LGB) asumidos tienen niveles de la hormona del estrés más bajos y menos síntomas de ansiedad, depresión y agotamiento, según...